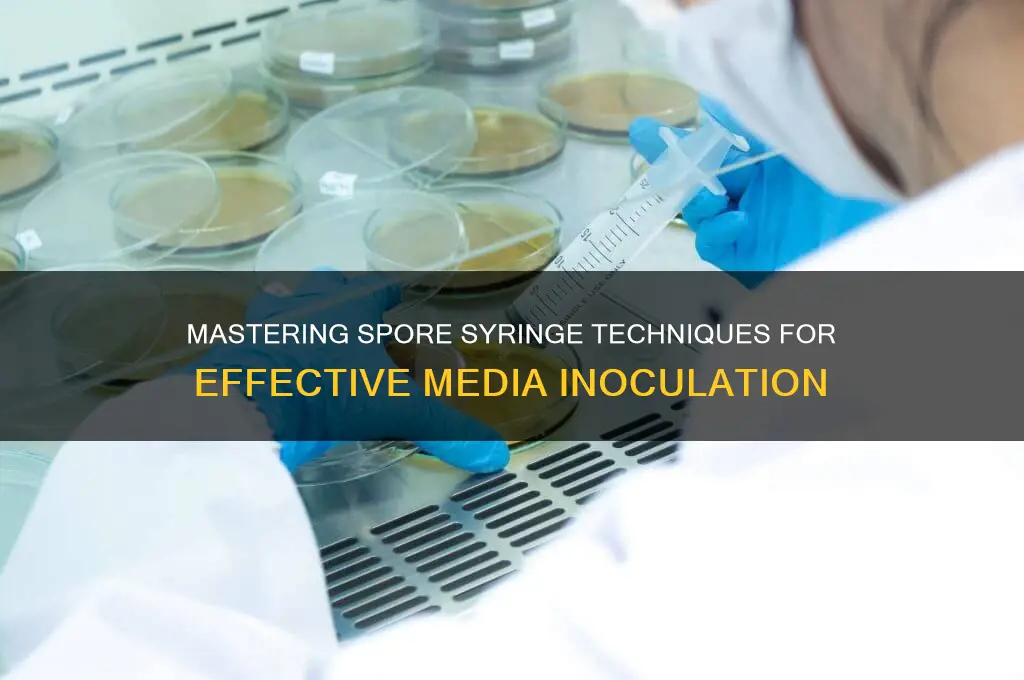
how to use a spore syringe in media

Using a spore syringe in media is a fundamental technique in mycology, allowing enthusiasts and researchers to cultivate mushrooms by inoculating a sterile substrate with fungal spores. The process begins by preparing a sterile growth medium, such as agar or grain spawn, which provides nutrients for the spores to germinate. The spore syringe, containing a suspended solution of spores in water, is then carefully injected into the medium, ensuring even distribution without contaminating the environment. Proper sterilization of tools and workspace is critical to prevent unwanted bacteria or molds from interfering with the growth. Once inoculated, the medium is sealed and placed in optimal conditions for incubation, where the spores develop into mycelium, the vegetative part of the fungus. This method is widely used in both home cultivation and scientific studies, offering a controlled and efficient way to propagate mushrooms for food, medicine, or research purposes.
| Characteristics | Values |
|---|---|
| Purpose | To inoculate sterile substrate with mushroom spores for cultivation |
| Sterility | Crucial; work in a sterile environment, use sterile tools, and flame sterilize the needle |
| Substrate Preparation | Sterilize substrate (e.g., grain, agar) before inoculation |
| Inoculation Technique | Inject 1-2 cc of spore solution per spawn bag/jar, distribute evenly |
| Injection Sites | Multiple small injections are better than one large one |
| Sealing | Seal injection sites with sterile micropore tape or alcohol |
| Incubation | Maintain optimal temperature (22-28°C) and humidity for mycelium growth |
| Contamination Prevention | Work in a still air box or laminar flow hood if possible |
| Storage | Store spore syringes in a cool, dark place (2-8°C) until use |
| Shelf Life | Spore syringes can last 6-12 months if stored properly |
| Common Mistakes | Over-injecting, poor sterilization, incorrect incubation conditions |
| Success Indicators | White, fluffy mycelium growth within 7-14 days |
| Safety | Wear gloves and a mask to avoid contamination and inhalation of spores |
| Legal Considerations | Check local laws regarding mushroom cultivation and spore possession |
| Alternative Methods | Agar inoculation, liquid culture inoculation |
What You'll Learn
- Sterilize workspace and equipment to prevent contamination during the inoculation process
- Prepare substrate by sterilizing it in advance for optimal spore colonization
- Inject spores using the syringe carefully to avoid damaging the mycelium
- Seal injection sites properly to maintain sterile conditions and prevent contamination
- Incubate media in a dark, controlled environment to encourage healthy mycelium growth

Sterilize workspace and equipment to prevent contamination during the inoculation process
Contamination is the arch-nemesis of successful inoculation, capable of derailing weeks of preparation in a matter of hours. Even a single stray bacterium or mold spore can outcompete your desired culture, rendering your efforts futile. This is why sterilization isn’t just a step—it’s the foundation of the entire process. Without a pristine workspace and equipment, your spore syringe is little more than a vessel for chaos.
Begin by designating a clean, enclosed area for your work. A laminar flow hood is ideal, but if unavailable, a makeshift sterile zone can be created using a clear plastic box or even a large storage container with a filtered air supply. Wipe down all surfaces with a 70% isopropyl alcohol solution, paying special attention to corners and edges where dust accumulates. Allow the area to dry completely before proceeding. For equipment, autoclaving is the gold standard, but for home cultivators, a 10-minute soak in 10% bleach solution followed by a thorough rinse with sterile water and a final wipe-down with alcohol will suffice.
Heat is your ally in this battle against microbes. Flame sterilization is a quick, effective method for metal tools like scalpels or tweezers. Pass the instrument through a bunsen burner flame until it glows red, then allow it to cool on a sterile surface. For glassware or items that can’t withstand direct flame, dry heat sterilization in an oven at 170°C (340°F) for 2 hours is recommended. Always handle sterilized equipment with gloved hands to maintain integrity.
Even the smallest oversight can introduce contaminants. Avoid wearing jewelry, tie back long hair, and don a lab coat or clean clothing to minimize particulate matter. Use a sterile spatula or syringe to transfer media, never touching the inoculation point directly. If using agar plates, seal them with parafilm immediately after inoculation. Remember, sterilization isn’t a one-time task—it’s a mindset. Every movement, every tool, every surface must be treated as a potential vector for contamination.
The takeaway is clear: sterilization isn’t optional; it’s the linchpin of successful inoculation. By meticulously cleaning your workspace, properly sterilizing equipment, and maintaining aseptic technique, you create an environment where your culture can thrive without competition. Skimp on this step, and you’re not just risking failure—you’re inviting it.
Effective Ways to Eliminate Mold Spores from Couch Cushions
You may want to see also

Prepare substrate by sterilizing it in advance for optimal spore colonization
Sterilizing your substrate is the cornerstone of successful spore colonization. Unsterilized substrate is a breeding ground for competing bacteria and fungi, which will outcompete your desired spores for resources. This results in contamination, stunted growth, or complete failure of your project. Think of it like planting seeds in a garden overrun with weeds – your desired plants won't stand a chance.
Sterilization methods vary depending on your substrate type and equipment. For most common substrates like grain, manure, or vermiculite, pressure cooking (autoclaving) is the gold standard. Aim for 15-30 minutes at 15 psi (pounds per square inch) to ensure all microorganisms are eradicated. If autoclaving isn't an option, consider pasteurization by boiling your substrate for at least an hour. While less effective than autoclaving, it can still significantly reduce contaminants. Remember, even a small amount of contamination can derail your entire project.
Let's compare the two main sterilization methods: autoclaving and pasteurization. Autoclaving, while more time-consuming and requiring specialized equipment, guarantees a sterile environment. It's ideal for serious cultivators or those working with sensitive species. Pasteurization, on the other hand, is more accessible and suitable for beginners or smaller-scale projects. However, it carries a higher risk of contamination and may not be sufficient for all substrates.
After sterilization, allow your substrate to cool completely before inoculation. Introducing spores to hot substrate will kill them instantly. Aim for a temperature between 70-80°F (21-27°C) for optimal spore germination. Think of it like planting seeds in freshly tilled soil – you wouldn't want to scorch them with hot earth.
Finally, remember that sterilization is just one step in the process. Maintaining sterile technique throughout inoculation and incubation is crucial. Work in a clean environment, use sterile tools, and avoid touching the substrate or spores with bare hands. With proper sterilization and careful handling, you'll create the ideal environment for your spores to thrive.
Mastering Milky Spore Propagation: A Step-by-Step Guide for Gardeners
You may want to see also

Inject spores using the syringe carefully to avoid damaging the mycelium
The delicate mycelium network is the lifeblood of your fungal cultivation, and injecting spores with a syringe requires a surgeon's precision. A single misstep can tear this intricate web, stunting growth or even killing your culture. Imagine threading a needle with a single hair – that's the level of care needed.
Use a sterile 10-20 ml syringe with a 16-18 gauge needle for optimal control. Gently depress the plunger, aiming for a slow, steady stream of spore solution. Think of it as painting with microscopic ink, not jabbing with a dagger.
The key lies in understanding the mycelium's fragility. This network, though resilient in its mature form, is incredibly delicate during colonization. Imagine a newborn's skin – strong in potential but easily damaged. A forceful injection can create channels, disrupting the mycelium's natural growth pattern and leaving it vulnerable to contamination.
Think of the substrate as a sponge. You want the spores to permeate gently, not be forced through like a blunt instrument.
Mastering this technique takes practice. Start with a small amount of spore solution (0.5-1 ml) and observe the flow. Adjust your pressure accordingly, aiming for a fine mist rather than a jet. If you encounter resistance, stop immediately. Withdraw the needle slightly and try again at a different angle. Remember, patience is paramount. A slow, deliberate approach ensures a healthy, thriving mycelium network, the foundation for a successful harvest.
Maximize Your Wealth: Proven Strategies to Earn More Money in Spore
You may want to see also

Seal injection sites properly to maintain sterile conditions and prevent contamination
Properly sealing injection sites is a critical step in using a spore syringe in media, as it directly impacts the success of your cultivation by preventing contamination. Even a single stray microbe can outcompete your desired fungi, rendering your efforts futile. To ensure sterile conditions, begin by sterilizing the injection site with a flame or 70% isopropyl alcohol. Once the syringe needle pierces the substrate, apply a sterile, self-adhesive Tyvek tape or a thin layer of melted agar around the entry point. This creates a barrier that seals out airborne contaminants while allowing the mycelium to grow unimpeded.
Consider the substrate’s composition when sealing injection sites. For example, if using a grain spawn, the moisture content and texture may require a more flexible sealing method, such as a liquid latex sealant, to accommodate expansion during colonization. In contrast, agar plates benefit from a quick, heat-sterilized scalpel cut sealed with parafilm, which adheres tightly to the glass or plastic surface. Always work in a still air box or laminar flow hood to minimize airborne particles during the sealing process, as even a momentary exposure can introduce contaminants.
A common mistake is over-sealing, which can restrict gas exchange and hinder mycelial growth. Aim for a balance: seal tightly enough to block contaminants but loosely enough to allow carbon dioxide and oxygen to flow. For instance, when injecting a bulk substrate like manure or coir, use a small piece of sterile cotton or a cotton swab dipped in alcohol to plug the hole, ensuring it’s snug but not compressed. This method is particularly effective for larger injection sites, where tape or agar might not adhere properly.
Finally, monitor sealed sites for signs of contamination, such as discoloration or unusual odors, which may indicate a breach. If contamination occurs, isolate the affected area immediately to prevent spread. Regularly practice aseptic technique, such as flaming the needle before and after each injection, to reduce the risk of introducing microbes. By mastering the art of sealing injection sites, you not only protect your culture but also streamline the cultivation process, saving time and resources in the long run.
Are Spores Independent Organisms or Survival Mechanisms?
You may want to see also

Incubate media in a dark, controlled environment to encourage healthy mycelium growth
After inoculating your substrate with a spore syringe, the incubation phase is critical for mycelium colonization. Think of this stage as the fungal equivalent of a seedling’s first weeks—delicate, dependent on stability, and highly susceptible to environmental stressors. The mycelium, a network of thread-like structures, requires darkness to direct energy toward growth rather than premature fruiting. Light triggers photosynthesis in plants but can confuse fungi, leading to erratic development or contamination. A controlled environment, ideally at 70–75°F (21–24°C) with 60–70% humidity, mimics the fungi’s natural habitat, ensuring optimal conditions for expansion. Fluctuations in temperature or humidity can stall growth or invite mold, so consistency is non-negotiable.
To set up incubation, choose a dark space like a closet or cabinet, or use an opaque container to block light. Avoid areas prone to drafts or temperature swings, such as near windows or vents. If using a still air box or incubator, monitor humidity with a hygrometer and adjust with a spray bottle or humidifier as needed. For small-scale projects, a simple shoebox lined with aluminum foil and a lid works well. Larger operations may require a dedicated incubation chamber with temperature and humidity controls. Regardless of scale, maintain sterility during setup—sanitize tools and hands, and work in a clean environment to prevent contamination.
The incubation period typically lasts 7–14 days, depending on the species and substrate. During this time, resist the urge to disturb the media. Opening the container introduces risks—airborne contaminants, light exposure, or temperature shifts can derail progress. Instead, observe through a small, opaque window or briefly lift the lid in a clean environment if absolutely necessary. Patience is key; mycelium grows invisibly at first, colonizing the substrate before becoming visible. Signs of success include a white, cobweb-like layer spreading across the surface, while green or black spots indicate contamination.
While darkness is essential, airflow remains a balancing act. Mycelium needs oxygen to thrive, but excessive ventilation can dry the substrate or introduce contaminants. If using a sealed container, ensure it’s not airtight—drill small holes or use a breathable material like micropore tape. For open setups, cover the substrate with a damp cloth or foil to retain moisture while allowing minimal air exchange. Overwatering is a common mistake; the substrate should be moist but not soggy, as excess water creates anaerobic conditions that fungi cannot tolerate.
In conclusion, incubation is a test of precision and restraint. By maintaining darkness, stable temperature, and humidity, you create an environment where mycelium can flourish undisturbed. This phase lays the foundation for fruiting bodies, so shortcuts or negligence here will undermine later efforts. Treat incubation as a partnership with the fungus—provide the right conditions, step back, and let nature take its course. With care, you’ll soon see the rewards of a healthy, vibrant mycelium network ready for the next stage.
Get Your Spore Galactic Adventures Confirmation Email: A Quick Guide
You may want to see also
Frequently asked questions
A spore syringe contains a suspension of mushroom spores in sterile water. It is used in media by injecting the spore solution into a sterilized substrate (like agar or grain) to initiate fungal growth for cultivation or research purposes.
Sterilize the media by autoclaving it at 121°C (250°F) for 30–60 minutes to kill any contaminants. Allow it to cool to around 25°C (77°F) before injecting the spore syringe to avoid killing the spores.
Sterilize the injection port or surface with alcohol, then insert the syringe needle and slowly inject the spore solution. Ensure the needle is fully inserted to distribute spores evenly, and seal the port immediately to maintain sterility.
Colonization time varies by species and conditions but typically takes 1–4 weeks. Maintain the media at the optimal temperature (usually 22–28°C or 72–82°F) and in a dark, sterile environment to encourage growth.







